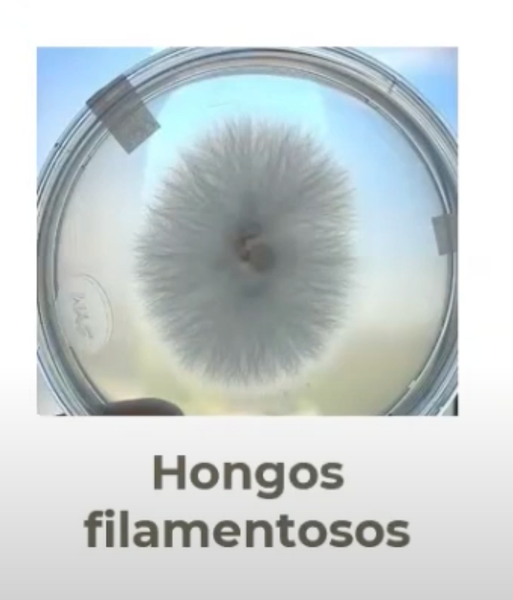
CPS080 - Hongos Filamentosos y su Tolerancia a Metales Pesados (Ag y Cu) como una Alternativa de Bi…

Chiapas 2025 Ponencias Virtuales
Academia Journals Chiapas 2025
CPS062 - Los Valores con que Cuentan los Estudiantes para Contribuir con la Sustentabilidad Ambient…
CPS066 - The Three Pillars of the FIRE Movement and Their Applicability Under Mexico's 2025 Economi…
CPS068 - Continuous Sliding Mode Control Applied to Trajectory Tracking for a Mobile Robot Autominy…
CPS080 - Hongos Filamentosos y su Tolerancia a Metales Pesados (Ag y Cu) como una Alternativa de Bi…
CPS083 - PROPOSAL FOR THE CONSTRUCTION OF A PYROLYTIC FURNACE TO OBTAIN BIOCHARCOAL BASED ON RESIDU…
CPS085 - Impact of learning rate on Feedforward Neural Network for Hubble Parameter estimation for …